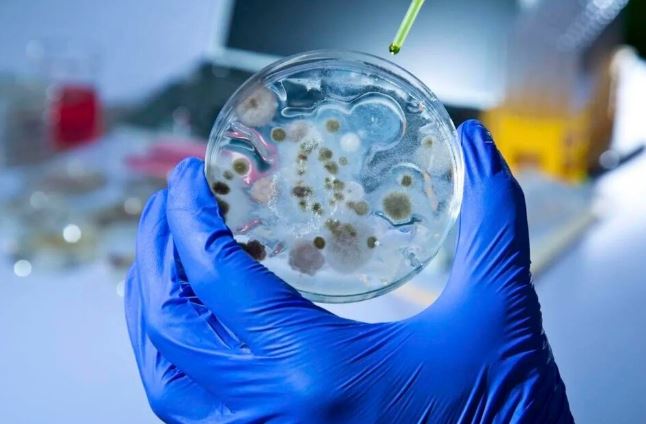

Según la Came, las ventas minoristas pymes cayeron 2,8% anual en mayo
La pérdida de poder adquisitivo de los argentinos a causa de la inflación golpea con fuerza a los comercios pymes
Las ventas minoristas pymes registraron un nuevo retroceso en mayo, que alcanzó el 2,8% frente al mismo mes del año pasado, medidas a precios constantes y se convirtió en la mayor caída del año. De esta manera, la racha negativa acumula cinco meses de manera consecutiva.
El Índice de Ventas Minoristas Pymes reveló que las ventas acumulan un declive del 1,7% en los primeros cinco meses del año, respecto al mismo periodo de 2022. En tanto que en la comparación mensual, los negocios también vendieron 1,2% menos que en abril.
Desde la Came advirtieron que "el sector comercial viene sintiendo cada vez más la pérdida de poder adquisitivo de las familias en manos de la inflación", señalando que "desde todos los negocios relevados manifestaron que recibieron productos con subas importantes de precios".
La entidad gremial-empresaria también remarcó que "el 56% tuvo problemas para reponer stock porque los proveedores demoraron entregas o directamente las cancelaron, según manifestaron en el sondeo".
En mayo, de los 7 rubros medidos, 6 cayeron en la comparación anual y solo uno creció. Mientras que en lo que va del año, 5 sectores acumulan caídas y solo 2 aumentos. El único rubro con crecimiento anual en mayo fue Farmacias (+6,4%), y entre los ramos en baja, el de mayor retracción fue Indumentaria y textil (-8,2%). Para el acumulado anual, se mantienen en alza Farmacias (+6,8%) y Ferreterías, materiales eléctricos y de la construcción (+0,5). El resto, todos están abajo del periodo enero-mayo de 2022, siempre medidos a precios constantes.